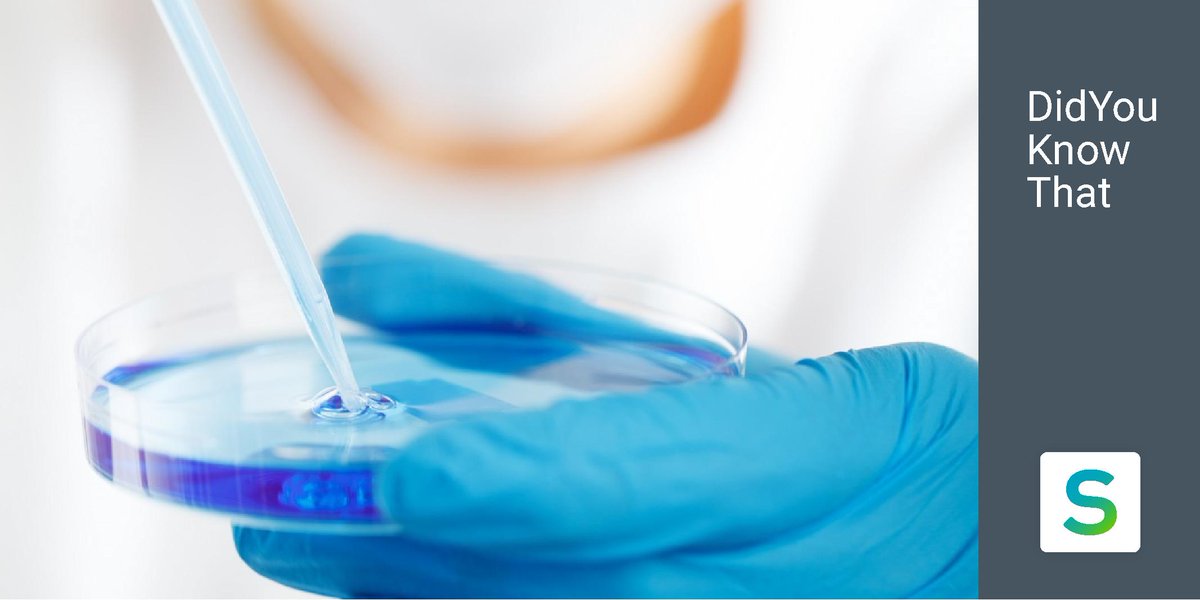
sciencestanding's tweet image. #DidYouKnowThat
Who invented the Petri dish? The most utilitarian lab instrument ever was created by German microbiologist Julius Richard Petri in 1887. They are used in scientific tests, especially for growing bacteria. 

#Biology #Microbiology #Research #eLearning #Science

Sciencestanding
@sciencestanding
Online education platform that provides engaging 3D & interactive medical scientific content 🔬 #Biology #Oncology #Medicine New App ➡️ #3DFacialProcedures
Bạn có thể thích
3D animation videos and interactive self-evaluation tests are key strengths of the course “Cellular and Molecular #Biology of #Cancer”. Check out the video below to find out more details. → Discover who we are, our mission and approach here: bit.ly/sciencestanding
MicroRNAs are non-coding #RNA molecules whose main function is to regulate the translation process. Learn the role that microRNAs play in the process of carcinogenesis with our free content: bit.ly/2E9W8sN #Sciencestanding #DNA #Biology #Oncology #Cancer #Medicine
#Autophagy is a catalytic process for recycling molecules and damaged organelles. It remains active as an intracellular quality control system and ensures cell homeostasis. Learn more with our free content: bit.ly/2SpBJD1 #Sciencestanding #Oncology #Biology #Medicine
Any scientific discovery requires many things 🔬 but first and foremost: a daring leap into the unknown 🦸♀️🦸♂️ #SciencestandingQuotes #Sciencestanding #Biology #Oncology #Medicine #Science #eLearning

Antimicrotubule agents are #chemotherapy drugs that act on #microtubules by blocking #cell division. There are two different therapeutic strategies. Learn more about Chemotherapy with our free content: bit.ly/2PeGjSI #Sciencestanding #Oncology #Biology #Cancer
#TumorImmunoediting describes the process through which tumor cells acquire the ability to escape the action of the #immunesystem and survive. As a result, the #tumor continues to grow. It occurs via two mechanisms (Video): bit.ly/2QyXsLz #Oncology #Cancer #Biology
Scientists from @harvardmed have discovered a suite of #molecules involved in #penicillin-induced bacterial bursting. The findings set the stage for developing new #antibiotics to kill #bacteria that have become impervious to current drugs: bit.ly/2SeZxL0 #Biology
hms.harvard.edu
Dynamite for Bacteria
How does penicillin detonate bacteria? Insights set stage for development of new antibiotics.
From 3D animations to VR simulators... #digital enhancements in medical scientific #education are transforming how students study and learn for the better. #Sciencestanding #Biology #Oncology #Medicine #eLearning

#Angiogenesis is the physiological process through which new #bloodvessels form from endothelial cells of pre-existing vessels. It is also fundamental in the transition of #tumors from a benign state to a malignant one: bit.ly/2QwrcZp #Oncology #Biology #Medicine
Researchers at the @kochinstitute have developed nanosized antibodies that target the extracellular matrix (ECM) of #cancer cells, as it has proven to play a key role in #tumor growth and progression: bit.ly/2YTxzHt #Sciencestanding #Biology #Oncology #Research
The #3DFacialProceduresApp presents middle third Volumization & Rejuvenation techniques in 3D to demonstrate anatomical danger zones for injection locations of the face. Explore other features: bit.ly/2FxcpHg #FacialAnatomy #Dermatology #Ophthalmology #PlasticSurgery

#Telomerase helps to keep cells alive by adding #DNA to #telomeres (the ends of chromosomes). This enzyme prevents #chromosomes from becoming damaged, eventually avoiding #cell death. Learn more: bit.ly/2Qzjeih #Sciencestanding #CellCycle #Biology #Oncology #Medicine
#DidYouKnowThat Who invented the Petri dish? The most utilitarian lab instrument ever was created by German microbiologist Julius Richard Petri in 1887. They are used in scientific tests, especially for growing bacteria. #Biology #Microbiology #Research #eLearning #Science
Pere Gascón, Director of the CELLEX Chair of #Oncology and Multidisciplinary Knowledge at @UniBarcelona, is the principal member of our #AdvisoryBoard, a prestigious body that ensures the scientific accuracy of our platform’s content. #Education #eLearning #Biology #Medicine
Scientific advances occur by thinking outside of the box: leave your comfort zone. #Sciencestanding #QuoteOfTheDay #Biology #Oncology #Medicine #eLearning #OnlineEducation

Receptor tyrosine kinases (RTKs) encompass several membrane proteins that function as the receptors for a wide array of growth factors, including epidermal growth factor (EGF), nerve growth factor (NGF) and platelet-derived growth factor (PDGF), among others. #Oncology #Biology
#3DFacialProceduresApp 3D pre-operative analysis provides an advanced view of safety harbors and adverse event zones of the midface, as well as the location and movement of the facial fat pads. Get the app: bit.ly/2FxcpHg #plasticsurgery #dermatology #ophthalmology

Good teachers always bring out the best in you. #sciencestanding #biology #oncology #elearning #education

#BrainMetastasis Some tumor cells are able to exit the cerebral blood vessels due to the intervention of several proteins such as cyclooxygenase 2. Learn more about it with our free content: bit.ly/2A6Jeam #Sciencestanding #Oncology #Biology #Cancer #eLearning
#3DOculoplastyProcedures 3D Facial Procedures features 3D animations that enable users to see the pearls of procedures from didactic perspectives and demonstrate fundamental knowledge of anatomy while learning complex periocular surgery. Get the app: bit.ly/2FxcpHg

Swimming against the tide is sometimes the only way to move forward. #Sciencestanding #Science #Medicine #Biology

United States Xu hướng
- 1. Black Friday 310K posts
- 2. #releafcannabis N/A
- 3. Good Friday 50.3K posts
- 4. #FanCashDropPromotion N/A
- 5. #DaesangForJin 55K posts
- 6. #AVenezuelaNoLaTocaNadie 1,011 posts
- 7. #ENHYPEN 202K posts
- 8. ARMY Protect The 8thDaesang 58.4K posts
- 9. Third World Countries 42.1K posts
- 10. Victory Friday N/A
- 11. yeonjun 67.1K posts
- 12. Mnet 209K posts
- 13. Sarah Beckstrom 263K posts
- 14. Cyber Monday 5,223 posts
- 15. Lamar 48.9K posts
- 16. TODAY ONLY 63.2K posts
- 17. Stormzy 2,020 posts
- 18. Mr. President 20.6K posts
- 19. Wegmans 2,377 posts
- 20. BNB Chain 6,768 posts
Something went wrong.
Something went wrong.





























































































